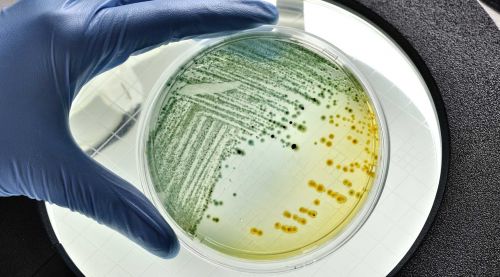
E coli

Tout comprendre sur les effets de la bactérie E. coli dans les aliments
Aliments contaminés par la bactérie E. coli : quels effets sur la santé et comment prévenir les infections ?
La bactérie Escherichia coli (E. coli) a récemment fait l’actualité en France, dans le cadre de l’importante vague d’intoxications alimentaires qu’elle a provoquée. Une épidémie due à des pizzas contaminées qui a touché 56 personnes, dont 55 enfants, et a provoqué deux décès. Dans un article publié dans The Conversation, notre scientifique Pauline Kooh revient sur le danger des E. coli entérohémorragiques et les aliments impliqués dans les épidémies.
Un nouveau test pour mieux détecter les E. coli pathogènes dans les aliments

L’Anses a mis au point une méthode de détection permettant de repérer plus rapidement et de façon plus ciblée les E. coli pathogènes dans les aliments, notamment dans les produits au lait cru. Grace à ces nouveaux marqueurs génétiques, le test développé par l’Anses permet de détecter les véritables souches d’Escherichia coli pathogènes en 24 h contre 4 jours auparavant. Ces travaux ont été publiés dans la revue International Journal of Food Microbiology.
Qu’est-ce que les Escherichia coli entérohémorragiques (EHEC) et comment s’en prémunir ?

Pour tout savoir sur les Escherichia coli entérohémorragiques et comment limiter notre exposition en tant que consommateur et en particulier pour les personnes sensibles, nous vous proposons un article décryptage.


